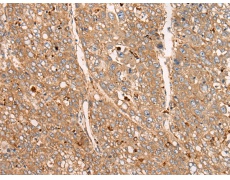
一抗

中文名稱: 兔抗APOBEC1多克隆抗體
|
Background: |
This gene encodes a member of the cytidine deaminase enzyme family. The encoded protein forms a multiple-protein editing holoenzyme with APOBEC1 complementation factor (ACF) and APOBEC1 stimulating protein (ASP). This holoenzyme is involved in the editing of C-to-U nucleotide bases in apolipoprotein B and neurofibromatosis-1 mRNAs. Multiple transcript variants encoding different isoforms have been found for this gene. |
|
Applications: |
ELISA, IHC |
|
Name of antibody: |
APOBEC1 |
|
Immunogen: |
Synthetic peptide of human APOBEC1 |
|
Full name: |
apolipoprotein B mRNA editing enzyme catalytic subunit 1 |
|
Synonyms: |
BEDP; HEPR; CDAR1; APOBEC-1 |
|
SwissProt: |
P41238 |
|
ELISA Recommended dilution: |
5000-10000 |
|
IHC positive control: |
Human liver cancer and human ovarian cancer |
|
IHC Recommend dilution: |
25-100 |


 購物車
購物車 幫助
幫助
 021-54845833/15800441009
021-54845833/15800441009